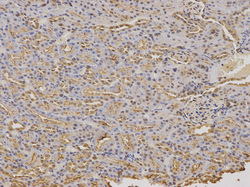

Antibody data
- Antibody Data
- Antigen structure
- References [0]
- Comments [0]
- Validations
- Western blot [1]
- Immunohistochemistry [10]
Submit
Validation data
Reference
Comment
Report error
- Product number
- LS-C331670 - Provider product page

- Provider
- LSBio
- Product name
- FXN / Frataxin Antibody LS-C331670
- Antibody type
- Polyclonal
- Description
- Affinity purified
- Reactivity
- Human, Mouse, Rat
- Host
- Rabbit
- Isotype
- IgG
- Storage
- Store at -20°C. Avoid freeze-thaw cycles.
No comments: Submit comment
Enhanced validation
- Submitted by
- LSBio (provider)
- Enhanced method
- Genetic validation
- Main image

- Experimental details
- Western blot analysis of extracts of various cell lines, using FXN antibody at 1:1000 dilution. The secondary antibody used was an HRP Goat Anti-Rabbit IgG (H+L) at 1:10000 dilution. Lysates were loaded 25ug per lane and 3% nonfat dry milk in TBST was used for blocking.
Supportive validation
- Submitted by
- LSBio (provider)
- Enhanced method
- Genetic validation
- Main image

- Experimental details
- Immunohistochemistry of paraffin-embedded human liver cancer using FXN antibody at dilution of 1:100 (200x lens).
- Submitted by
- LSBio (provider)
- Enhanced method
- Genetic validation
- Main image

- Experimental details
- Immunohistochemistry of paraffin-embedded rat kidney using FXN antibody at dilution of 1:100 (200x lens).
- Submitted by
- LSBio (provider)
- Enhanced method
- Genetic validation
- Main image

- Experimental details
- Immunohistochemistry of paraffin-embedded rat heart using FXN antibodyat dilution of 1:100 (40x lens).
- Submitted by
- LSBio (provider)
- Enhanced method
- Genetic validation
- Main image

- Experimental details
- Immunohistochemistry of paraffin-embedded mouse heart using FXN antibodyat dilution of 1:100 (40x lens).
- Submitted by
- LSBio (provider)
- Enhanced method
- Genetic validation
- Main image

- Experimental details
- Immunohistochemistry of paraffin-embedded rat heart using FXN antibodyat dilution of 1:100 (40x lens).
- Submitted by
- LSBio (provider)
- Enhanced method
- Genetic validation
- Main image

- Experimental details
- Immunohistochemistry of paraffin-embedded mouse heart using FXN antibodyat dilution of 1:100 (40x lens).
- Submitted by
- LSBio (provider)
- Enhanced method
- Genetic validation
- Main image

- Experimental details
- Immunohistochemistry of paraffin-embedded human liver cancer using FXN antibody at dilution of 1:100 (200x lens).
- Submitted by
- LSBio (provider)
- Enhanced method
- Genetic validation
- Main image
- Experimental details
- Immunohistochemistry of paraffin-embedded rat kidney using FXN antibody at dilution of 1:100 (200x lens).
- Submitted by
- LSBio (provider)
- Enhanced method
- Genetic validation
- Main image

- Experimental details
- Immunohistochemistry of paraffin-embedded rat heart using FXN antibodyat dilution of 1:100 (40x lens).
- Submitted by
- LSBio (provider)
- Enhanced method
- Genetic validation
- Main image

- Experimental details
- Immunohistochemistry of paraffin-embedded mouse heart using FXN antibodyat dilution of 1:100 (40x lens).